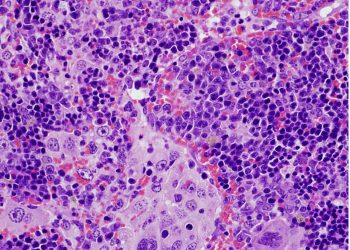

El trastorno del espectro autista se asocia a una alteración del microbioma intestinal en niños
La relación entre el microbioma intestinal y el trastorno del espectro autista (TEA) no es nueva, pero las investigaciones previas se han centrado en los cambios en la composición de las bacterias intestinales en personas afectadas en comparación con individuos considerados neurotípicos. De hecho, hasta ahora no estaba…
10/07/2024